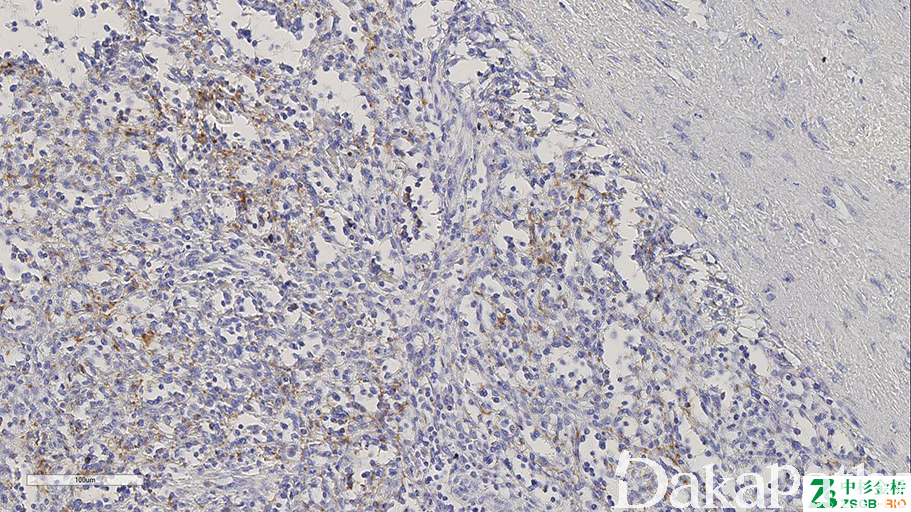

CD61

别名: integrin beta 3 chain (ITGB3)、GPIIIa
概述:
与 CD41 结合形成血小板糖蛋白 Iib/IIIa 复合体,参与凝血及血栓形成。骨髓巨核细胞及血小板的标记物,也可标记髓系、内皮细胞等。对过度脱钙敏感,可以作为脱钙程度的内参。
信号定位: 胞膜、胞浆
在病理学中的应用:
骨髓活检中小巨核细胞的识别;
急性巨核细胞白血病的诊断;
血小板无力症中 CD61 表达很少或几乎不表达。
- Identify platelets, megakaryocytes and platelet thrombi
- Distinguish TTP (diffuse CD61+ platelet rich thrombi) from DIC (no / sparse thrombi, Cardiovasc Pathol 2005;14:150)
- Count platelets in thrombocytopenic patients (Br J Haematol 2001;112:584)
商品化试剂(排名不分先后,本网站对抗体质量不负责!)
公司 | 克隆号 | 即用型(ml) | 原液(ml) | ||||
基因科技 | 2f2 | / | 2 | 4 | 7 | / | 0.2 |
赛诺特 | 2f2 | 1 | 3 | 6 | / | 0.1 | 0.2 |
中杉金桥 | 2f2 | 1.5 | 3 | 6 | / | 0.1 | 0.2 |
安必平 | 2f2 | 1.5 | 3 | 6 | / | 0.1 | 0.2 |
福建迈新 | 2f2 | 1.5 | 3 | 6 | / | / | 0.2 |
在肿瘤中的表达情况:
通常阳性(<95%,≥75%的病例阳性): 急性巨核细胞白血病
几乎全部阴性(<5%的病例阳性): 急性髓系白血病,NOS、皮肤基底细胞癌、B 淋巴母细胞白血病/淋巴瘤、Burkitt 淋巴瘤、急性髓系白血病(M2)、急性髓系白血病(M5)、急性髓系白血病(M4)、急性髓系白血病(M6)、急性髓系白血病(M3)、急性髓系白血病(M1)、急性嗜碱粒细胞白血病、慢性嗜酸细胞白血病
